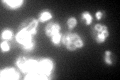
YEL051W
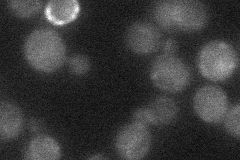
YEL051W
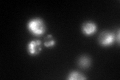
YEL051W
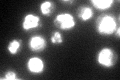
YEL051W

View description
Subunit D of the eight-subunit V1 peripheral membrane domain of the vacuolar H+-ATPase (V-ATPase), an electrogenic proton pump found throughout the endomembrane system; plays a role in the coupling of proton transport and ATP hydrolysis
Localization:
Intensity:
Fold change:
Significance:
-
C’ GFP library in SD
vacuole membrane95.5 -
N' NOP1pr-GFP in SD

below threshold58.7086 -
N' TEF2pr-mCherry in SD

below threshold0 -
N' NATIVEpr-GFP in SD
below threshold16.4722 -
N' TEF2pr-VC and Cyto-VN in SD

#N/A0 -
C’ GFP library in SD+DTT
vacuole membrane104.651.09No -
C’ GFP library in SD+H2O2

vacuole membrane98.31.02No -
C’ GFP library in Starvation Media
vacuole membrane246.72.58Yes -
C’ GFP library on the background of Pup2-DaMP

vacuole membrane -
C’ GFP library on the background of CCT mutant

vacuole membrane107.6011.12666No
